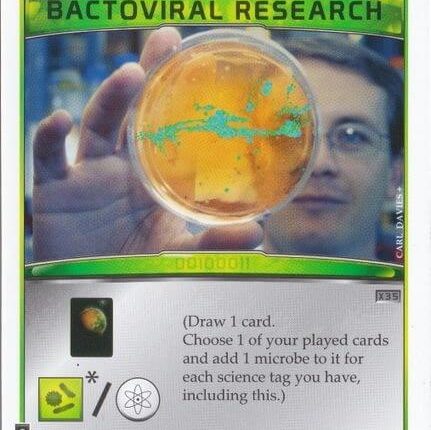

Jogo Terraforming Mars: Bactoviral Research – Promo Card (2021): o que é, onde comprar e quanto custa?
Interessado no Terraforming Mars: Bactoviral Research – Promo Card, jogador? Confira aqui as informações mais importantes sobre este jogo da FryxGames e comece a se divertir com seus amigos!
Lembrando que o jogo de tabuleiro Terraforming Mars: Bactoviral Research – Promo Card é um jogo pensado para pessoas com idade a partir de 12 anos e é indicado para 1 a 5 jogadores, além de ter sessões de jogo que duram em média 02 horas.
Conteúdo
Comercialmente, a descrição veiculada do jogo é essa:
Carta Promocional de Verão/2021. Disponível no FryxGames Web Shop entre 01/06 e 31/08 Ação: Compre 1 carta. Escolha uma das suas cartas jogadas e adicione 1 Micróbio a ela para cada etiqueta científica que você tiver, incluindo esta. “Desenvolvimento de genes e design de celulas para microorganismos.” Dependência de Idioma Moderado, precisa de uma planilha traduzida ou cartas traduzidas. Domínios Jogos Expert Mecânicas Colecionar Componentes, Colocação de Peças, Gestão de Mão, Jogadores com Diferentes Habilidades, Seleção de Cartas, Toma essa Categorias Expansão ou Suplemento Temas Economia / Produção, Ficção Científica
Mas não esqueça de ler os comentários para saber o que os jogadores realmente acham deste jogo de tabuleiro, assim como para deixar o seu review completo, ok?
O que poucos falam sobre Terraforming Mars: Bactoviral Research – Promo Card, é que ele tem em si diversas mecânicas, como: 1 Carta Sleeves 1 (63.5 mm X 88.0 mm) – o que enriquece a dinâmica entre os jogadores, oferecendo experiências únicas e ótimas lembranças, principalmente para aqueles com idade de 12 anos, pois são justamente o público alvo.
Isso é possível graças ao design de , que em conjunto com sua equipe (Jacob Fryxelius), criaram um jogo incrível!
Além da embalagem do Terraforming Mars: Bactoviral Research – Promo Card, também estão presentes no conteúdo do jogo os seguintes componentes:
1 Carta Sleeves 1 (63.5 mm X 88.0 mm).
Tire todas as suas dúvidas sobre o jogo Terraforming Mars: Bactoviral Research – Promo Card e veja como extrair o máximo de diversão sozinho ou com seus amigos.
A editora responsável pela distribuição do Terraforming Mars: Bactoviral Research – Promo Card (2021) foi a FryxGames no ano de 2021.
As sessões do Terraforming Mars: Bactoviral Research – Promo Card podem divertir seus jogadores por em média 02 horas.
Os designers e artistas que criaram as artes do Terraforming Mars: Bactoviral Research – Promo Card (2021) são Jacob Fryxelius em conjunto com Isaac Fryxelius.
O número mínimo para se jogar o Terraforming Mars: Bactoviral Research – Promo Card é de 1 e pode ser jogado por até no máximo 5 jogadores.
O jogo foi lançado pela editora FryxGames no ano de 2021.
A idade recomendada para que você possa jogar e se divertir com o jogo Terraforming Mars: Bactoviral Research – Promo Card é de 12 anos ou mais.
O número máximo de jogadores que podem se divertir com o jogo Terraforming Mars: Bactoviral Research – Promo Card (2021) são 1 jogadores.